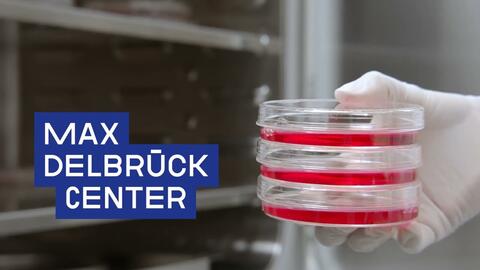

Videos aus dem MDC

Multimedia Tierversuche & 3R
/de/ueber/werte/tierversuche-ethik/transparent-kommunizieren/multimedia-tierversuche-3r

Lunch Break
/de/themen/lunch-break

Labor trifft Lehrer*in – digital!
/de/transfer/oeffentlichkeit/schule/ltl#t-videos

Lange Nacht der Wissenschaften
/de/lange-nacht#t-videos

Berlin Science Week
/de/science-week#t-videos
Weitere Videos
- Diversität am Max Delbrück Center
- Was Diversität für unsere Mitarbeiter*innen bedeutet!
- © Felix Petermann, Max Delbrück Center
- Corona-Forschung am Max Delbrück Center
- MDC-Forscher*innen beantworten COVID-19-Fragen. →
- Unsere Forschung
- Wissenschaftlerinnen und Wissenschaftler des MDC geben Einblick in ihre Forschung. →
-
Warum fällt es manchen Menschen leichter, fit und gesund zu bleiben? Das könnte mit unseren Darmbakterien zusammenhängen. Ein Vortrag von Sofia Forslund-Startceva auf dem 37. Chaos Communication Congress (37C3).
In diesem Jahr feiert die #Helmholtz-Gemeinschaft den 200. Geburtstag von Hermann von Helmholtz. Unter dem liebevollen Kosenamen #HäkelHermann erkundete jetzt eine gehäkelte Puppe im Helmholtz-Look einige der Mitgliedsinstitute – so auch das #mdcBerlin. Dort ging es in die Labore der AG Junker, die sich mit "Quantitativer Entwicklungsbiologie" auseinandersetzt. Mehr im Video!
Mit einer neuen Gen-Editing-Technik können Mutationen in Muskelstammzellen korrigiert werden, was den Weg für die erste potenzielle Zelltherapie für genetisch bedingte Muskelkrankheiten ebnet. Das ECRC-Team unter der Leitung von Professor Simone Spuler hat seine Ergebnisse in der Zeitschrift "JCI Insight" veröffentlicht.
Warum dauert es so lange, bis aus Grundlagenforschung eine Therapie wird? Für uns war diese Frage der Ausgangspunkt für einen Film, in dem wir den langen Weg einer Forschung gegen Krebs am MDC nachzeichnen:
Weitere Informationen zum Film
Der lange Atem – ein Film mit Thomas Blankenstein, Elisa Kieback, Mathias Leisegang, Antonio Pezzutto und Wolfgang Uckert
- Willkommen am Max Delbrück Center
- Unsere neue Arbeitsgruppenleiter*innen stellen sich vor. →
- © Felix Petermann, MDC
Seit Anfang Juni leitet Fabian Coscia die Nachwuchsgruppe Spatial Proteomics am MDC. Er analysiert mit Hilfe künstlicher Intelligenz das #Proteom von Tumorzellen – also die Gesamtheit aller Proteine, die #Krebszellen produzieren. Diese Methode will er nun im Projekt #MSTARS weiterentwickeln.
- Geschichte des Max Delbrück Centers
- Das Centrum und der Campus stecken voller Geschichte. →
Wissenschaft im Centrum: 2019 haben wir feierlich ein neues Haus im Herzen Berlins eröffnet – und haben damit einen zweiten Standort. Der Festakt beginnt mit einer Ansprache von Bundeskanzlerin Dr. Angela Merkel.
- Die Folgen der Gentechnologie und CRISPR/Cas: Wollen wir ewig leben?
- Emilia Tikka war 2018 als Artist in Residence am MDC. Ihr Kunstwerk und eine anschließende Konferenz sind in unseren Videos dokumentiert. →
Das Ergebnis von Emilia Tikkas Kunstaufenthalt zum Thema Gentechnik am MDC und die Wissenschaft dahinter: das Kunstwerk, ein Mini-Symposium und eine Podiumsdiskussion.
- Breaking Boundaries
- In der Veranstaltungsreihe „Breaking Boundaries“ geht es um das Aufbrechen der Grenzen zwischen Wissenschaft, Medizin, Kunst, Politik und Öffentlichkeit. →
- Inspirierende Wissenschaftlerinnen am Max Delbrück Center
- Das Berliner Institut für Gesundheitsforschung hat im Jahr 2018 Wissenschaftlerinnen begleitet, um einen Einblick in ihre Forschung zu erhalten. →
- © BIH© Berlin Institute of Health
- Vorträge am Max Delbrück Center
- Immer wieder sprechen hochkarätige Gäste am MDC. Hier sind ihre Vorträge dokumentiert. →
Der Vortrag des Nobelpreisträgers Thomas Südhof am MDC
- Mein 9. November
- Dreißig Jahre nach der gewaltfreien Revolution und dem Fall der Mauer veröffentlicht das MDC Augenzeugenberichte, Erinnerungen und Reflexionen von Mitarbeiterinnen und Mitarbeitern. →
- Adventskalender
- Wissenschaftler*innen des MDC sprechen über ihre Arbeit, ihre Urlaubspläne und Weihnachtsbräuche. →